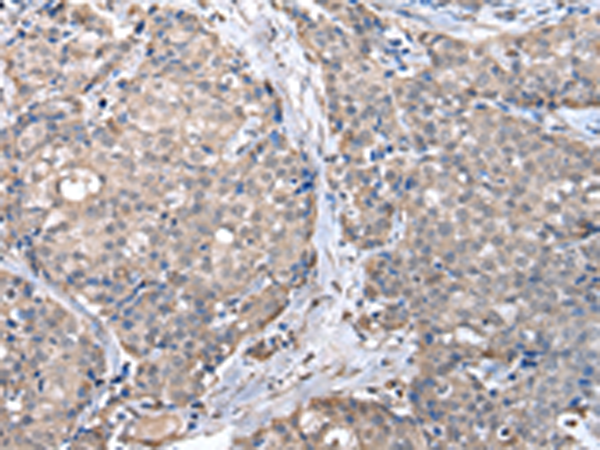

中文名稱(chēng) : 兔抗ZFP2多克隆抗體
技術(shù)規(guī)格
Background:
Probable transcription factor involved in neuronal differentiation and/or phenotypic maintenance.
Applications:
ELISA, IHC
Name of antibody:
ZFP2
Immunogen:
Fusion protein of human ZFP2
Full name:
ZFP2 zinc finger protein
Synonyms:
ZNF751
SwissProt:
Q6ZN57
ELISA Recommended dilution:
2000-10000
IHC positive control:
Human breast cancer
IHC Recommend dilution:
30-150
購(gòu)物車(chē)
購(gòu)物車(chē) 幫助
幫助
 021-54845833/15800441009
021-54845833/15800441009
